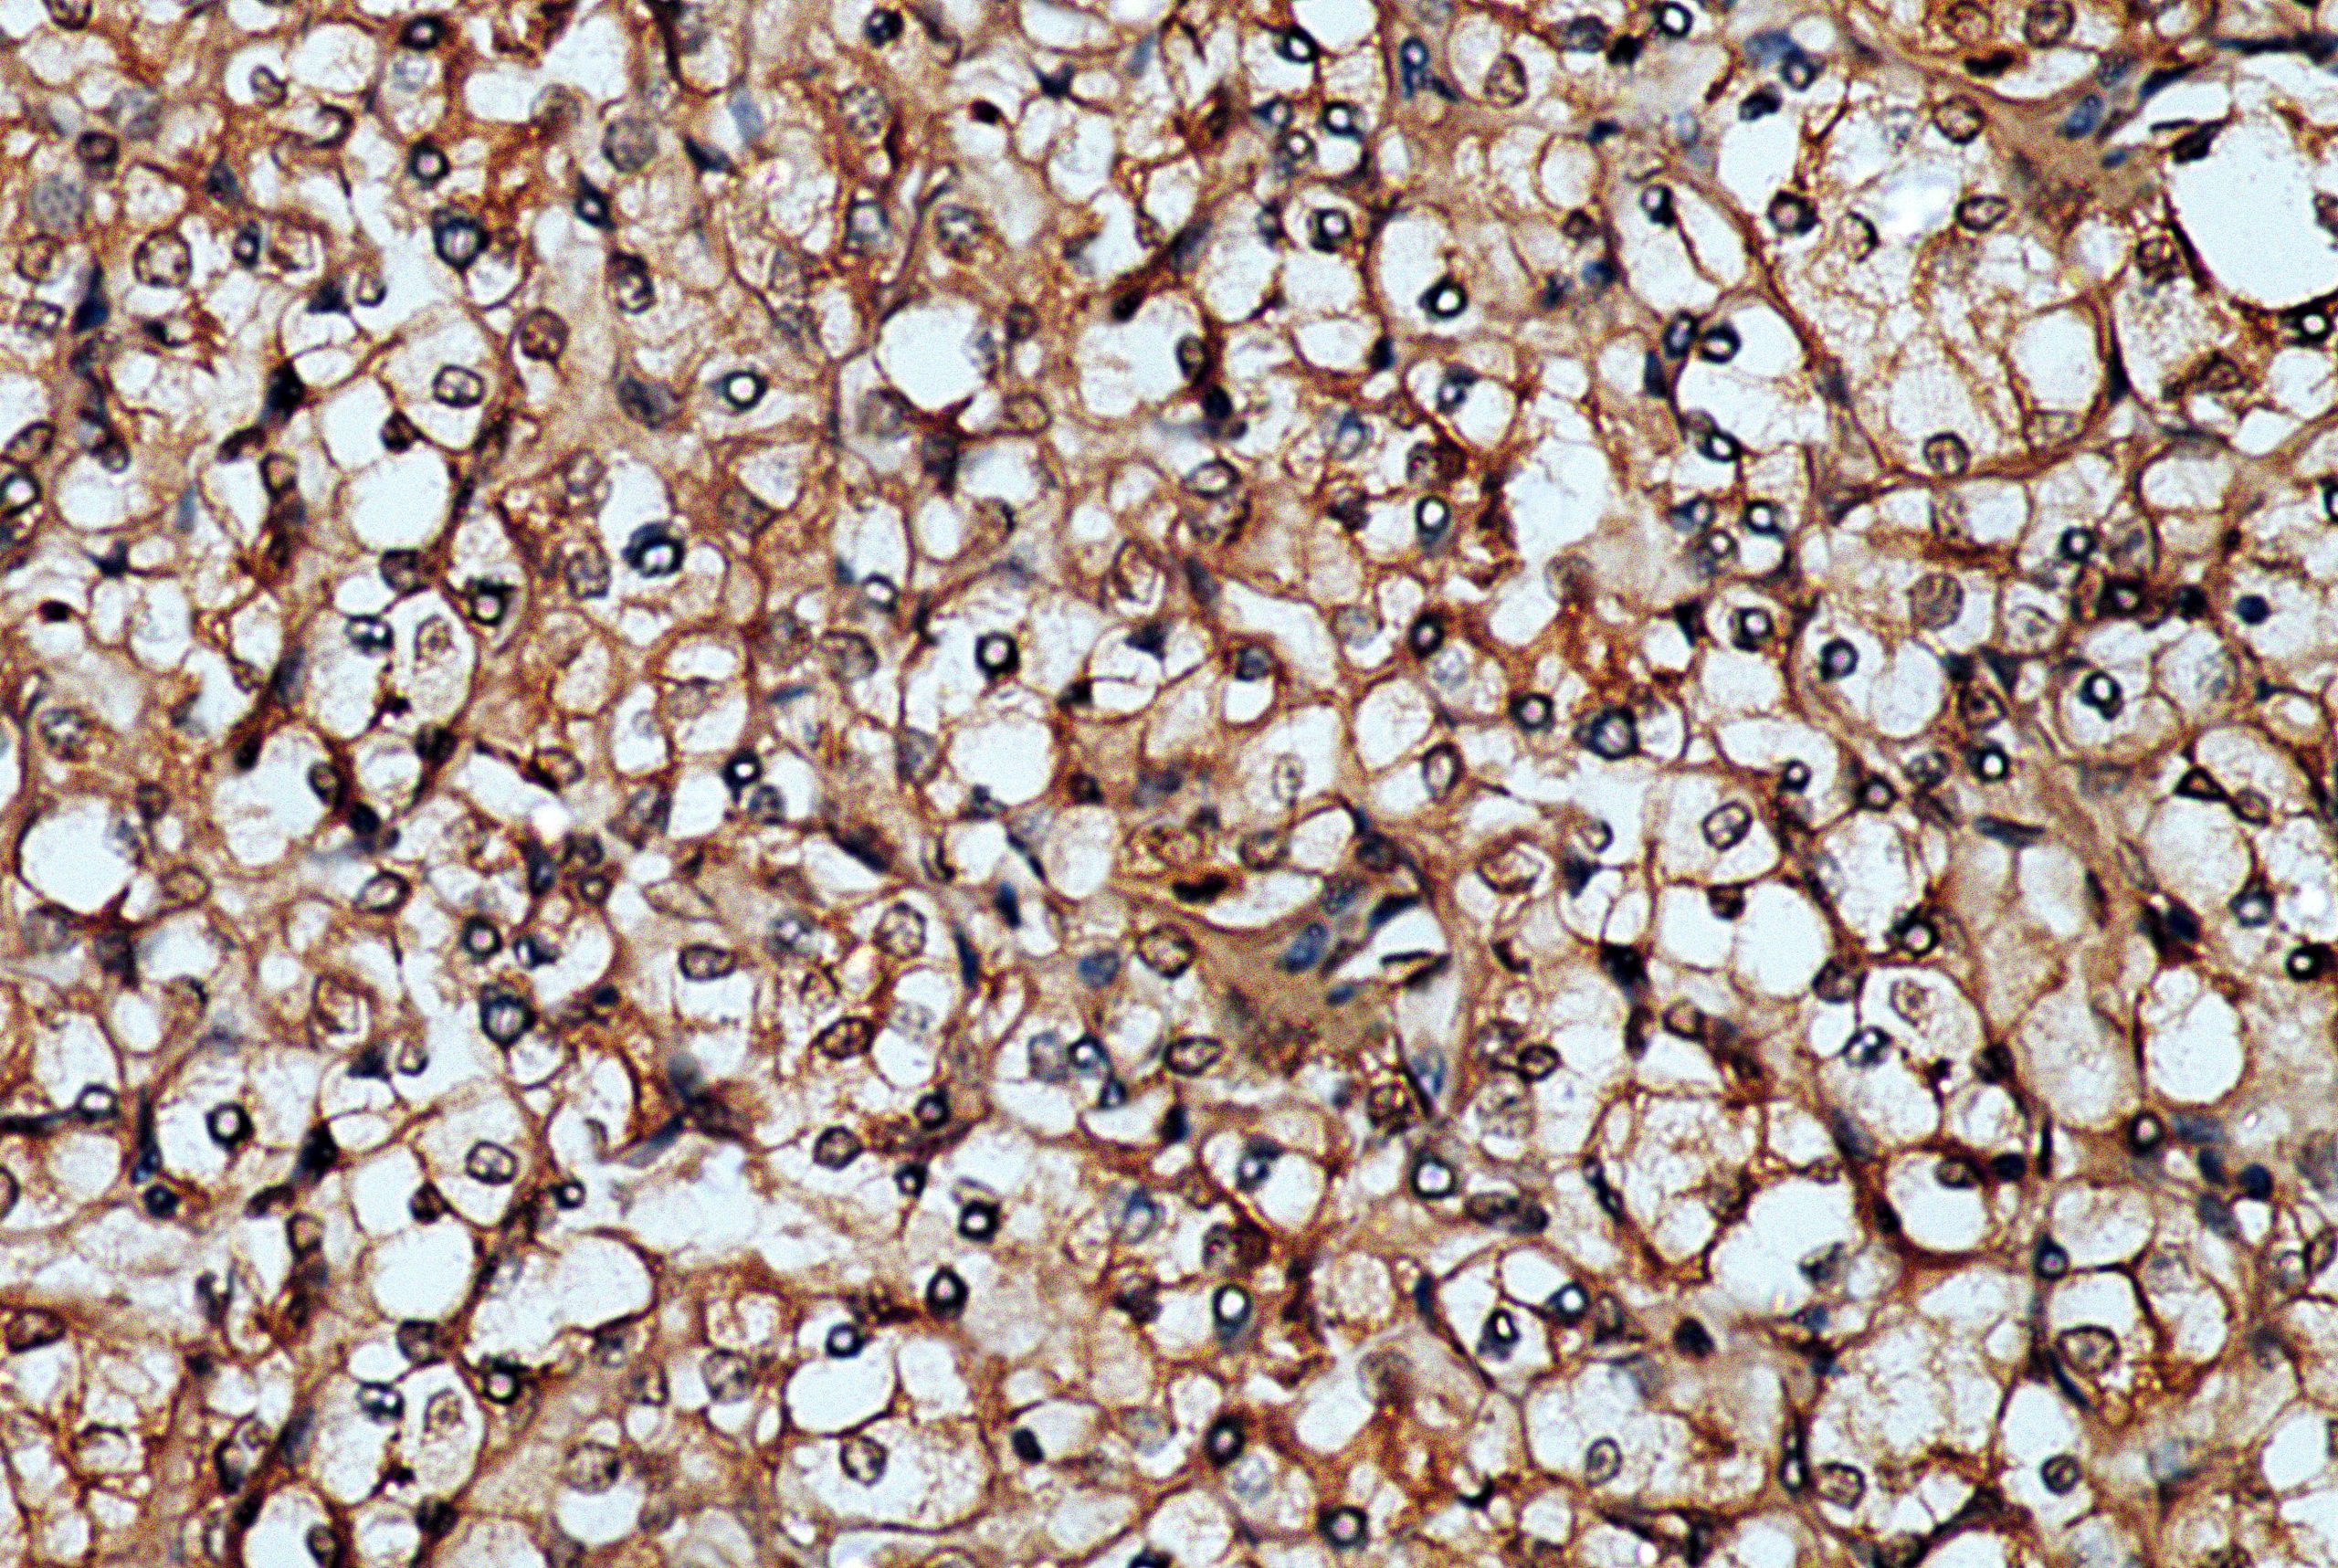
AMB33

Anti- Clusterin, Clone A-9
Clusterin, also known as Apolipoprotein J, Sulfated Glycoprotein 2 (SGP-2), TRPM-2, and SP-40,40, is a secreted
multifunctional glycoprotein that is expressed ubiquitously in most tissues. The main function of clusterin is to interact and stabilize stress-induced proteins to prevent them from precipitation. Additionally, it participates in the control of cell proliferation, apoptosis, and carcinogenesis. The subcellular distribution of multiple isoforms leads to the diversity of clusterin functions. Clusterin is secreted as a disulfide-linked heterodimer of alpha and beta chains and circulates as a component of high density lipoprotein (HDL) particles. Clusterin exerts tissue protective functions in atherosclerosis and Alzheimer?s disease by binding and neutralizing non-oxidatively modified LDL reduces cytotoxicity and beta-amyloid fibrils, respectively. Increased circulating levels of Clusterin enhancetumor aggressiveness by inhibiting apoptosis and by promoting epithelial to mesenchymal transition. Clusterin expression is observed in adult testis, ovary, adrenal gland, liver, heart, and brain and in many epithelial tissues during embryonic development.
| Intended Use | IVD |
|---|---|
| Antibody Type | Monoclonal |
| Source | Mouse |
| Clone | A-9 |
| Tissue Type | Tonsil tissue |
| Pack | 0.5 mL – Manual – Concentrate, 1 mL – Manual – Concentrate, 6 mL – Manual – RTU, 50 Tests – Automation – Xmatrx, 100 Tests – Automation – i6000, 160 Tests – Automation – Xmatrx, 5 slides – Xmatrx, 5 slides – Manual, 50 tests – NanoVIP® |